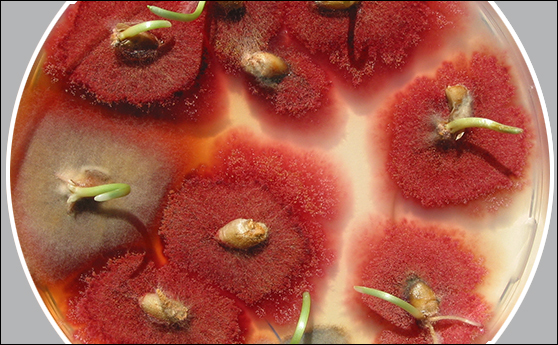
Copyright Agroscope - Colonies de Fusarium graminearum provenant de grains de blé.

Main Content
Les articles d'AGIR
Recherche - Prévention des mycotoxines (toxines fongiques) dans les grandes cultures
Le champignon Fusarium graminearum est l’un des pathogènes les plus importants des cultures céréalières. En Suisse, le blé, le triticale et le maïs sont cultivées sur environ 60 % des terres arables ouvertes ce qui fait que la rotation étroite des cultures de maïs et de céréales favorise les infections dues au Fusarium car les deux espèces cultivées sont sensibles à ce champignon, explique Agroscope aujourd’hui dans un communiqué.
De telles infections entraînent la formation de toxines fongiques (mycotoxines) qui constituent une menace pour la santé humaine et de l’animal. C’est la raison pour laquelle les scientifiques ont cherché des stratégies pratiques et durables pour lutter contre la fusariose. Ils ont montré que l’antagoniste au Fusarium, le champignon Clonostachys rosea, présent en Suisse, permet de supprimer le Fusarium sur les résidus de récoltes de maïs.
Afin de provoquer une infection au Fusarium, les experts d’Agroscope ont placé des tiges de maïs infectées sur la parcelle (infection semi-naturelle). Il ont alors observé que le Clonostachys rosea a permis de réduire la production de déoxynivalénol, une mycotoxine fusarienne, jusqu’à 90 % dans le champ.
Dans une nouvelle série de tests, les chercheurs ont décidé d’examiner pour la première fois l’utilisation de C. rosea directement durant le broyage. Ainsi, lors du broyage, les résidus de récolte sont concassés et laissés dans le champ. L’objectif recherché est de développer une solution applicable et durable en une seule étape. Pour ce faire, détaille Agroscope, les experts étudieront comment évoluent l’établissement du Clonostachys, l’infection par le Fusarium, le rendement agricole et la contamination par les mycotoxines dans le blé.
Plus d’information : https://www.agroscope.admin.ch/agroscope/fr/home/actualite/newsroom/2019/lutter-contre-champignons.html
AGIR/SP